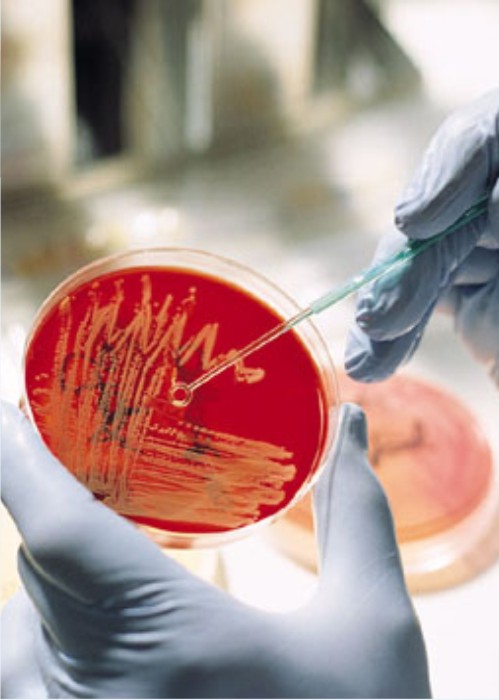
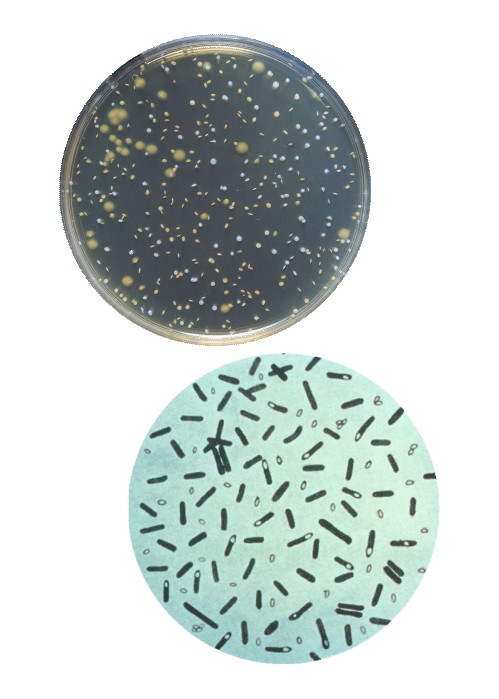

About us
Amspro Biotech established in the year of 2010 by professional Microbiologists who has more than 15 years of experience in R&D and manufacturing of Probiotics for Human and Animal healthcare. It is a biotech company with strong focus on Research, development and manufacturing of Probiotics and its formulations.
The core strength of our company is our R&D. We isolate large number of microbial strains from culture animals & environment and study their probiotic characteristics. Based on their probiotic attributes, we select strains and make a consortia of strains with high concentrations to develop problem specific formulations. Our technical competency and R&D activities enables us to understand the problems and provide cost effective solutions in the shortest period of time as per the need of any given situation. We take advantage of our accumulated expertise and experience to continue improving the quality of our products and introducing problem specific products.
Our products are manufactured according to unique processes and product flows. Therefore, we believe in-house production by our own dedicated and experienced staff to ensure the highest possible quality.
Amspro Biotech has developed path-breaking products that have been well accepted by Aqua farmers. We understand the difficulties of Farmers and therefore try our best to provide best solutions. We not only provide strong technical support for the products we sell but we are also eager to share whatever knowledge we have gathered in our endeavor to help better the customer's farming practices.
We have an excellent technical sales team that travels all over India to provide service and support to our customers. We are on the ground with the farmers and try to anticipate and solve problems before they occur.
Our products contain well-balanced formulation of bacteria and enzymes that work in various niche environments. They are field tested in a real aquaculture environment to ensure viability.
We consistently maintain highest standards for all our products. All our products are backed with technical support provided by qualified, trained and experienced professionals.
VISION & MISSION:
VISION
- Our vision to develop Amspro Biotech as a global biotechnological company
- To produce Eco-friendly, unique and high quality biotech products by continuous R&D Activities.
- To provide high returns to the farmers, employees and all others who are associated with this company.


MISSION
"To develop, manufacture and sell a wide range of highest quality healthcare Products for Aqua and Animal healhcare at realistic prices in order to make a substantial contribution to the reduction of costs for the farmers."